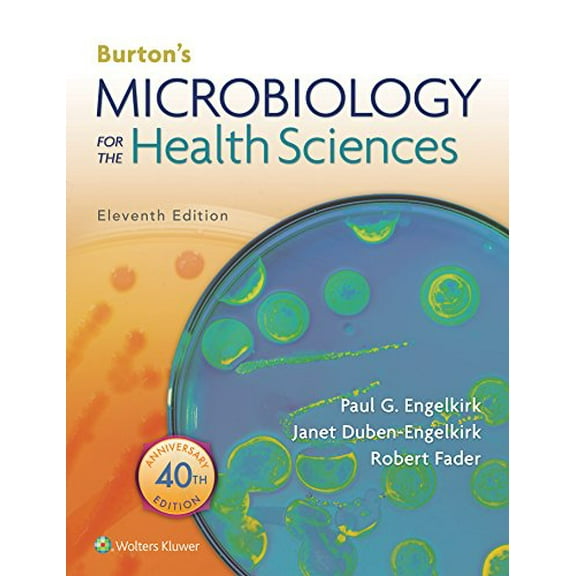
Pre-Owned Fader Burton's Microbiology for the Health Sciences 11th Edition Text + Prepu Package

Pre-Owned BooksReference BooksAges 6-8 Kids' BooksAllied Health Services BooksDentistry BooksDictionaries & Terminology BooksEducation BooksGeneral Educational BooksMedical BooksMicrobiology BooksNursing BooksPathophysiology BooksPregnancy & ChildbirthScience BooksShop all AudiobooksSports Medicine Books
Sort by|
Pre-Owned BooksReference BooksAges 6-8 Kids' BooksAllied Health Services BooksDentistry BooksDictionaries & Terminology BooksEducation BooksGeneral Educational BooksMedical BooksMicrobiology BooksNursing BooksPathophysiology BooksPregnancy & ChildbirthScience BooksShop all AudiobooksSports Medicine Books
Prepu(19)
Uses item details. Price when purchased online
NCLEX-PN 5000 PrepU Access Code $152.99

$15299
current price $152.99NCLEX-PN 5000 PrepU Access Code
15 out of 5 Stars. 1 reviews
Pre-Owned PREPU: PrepU for ACSM's Resources for the Personal Trainer (Edition 5) (Miscellaneous print) $126.99

$12699
current price $126.99Pre-Owned PREPU: PrepU for ACSM's Resources for the Personal Trainer (Edition 5) (Miscellaneous print)
PrepU for Abrams' Clinical Drug Therapy, 9781496371195, Paperback, 11th $8.00

$800
current price $8.00PrepU for Abrams' Clinical Drug Therapy, 9781496371195, Paperback, 11th
Pre-Owned PrepU Kyles's Essentials of Pediatric Nursing Paperback $16.81

$1681
current price $16.81Pre-Owned PrepU Kyles's Essentials of Pediatric Nursing Paperback
Pre-Owned Lippincott's NCLEX-RN 10,000 - Powered by PrepU $111.79

$11179
current price $111.79Pre-Owned Lippincott's NCLEX-RN 10,000 - Powered by PrepU
Pre-Owned What is Life? Guide to Biology (Loose Leaf) with PrepU NonMajors Access Card $12.49

$1249
current price $12.49Pre-Owned What is Life? Guide to Biology (Loose Leaf) with PrepU NonMajors Access Card
Pre-Owned Hogan-Quigley Bates' Nursing Guide + PrepU $80.49

$8049
current price $80.49Pre-Owned Hogan-Quigley Bates' Nursing Guide + PrepU
Pre-Owned ACSM's Resources for the Personal Trainer plus PrepU $81.99

$8199
current price $81.99Pre-Owned ACSM's Resources for the Personal Trainer plus PrepU
Pre-Owned Abrams' Clinical Drug Therapy 10th Ed.+ PrepU Access Code $84.49

$8449
current price $84.49Pre-Owned Abrams' Clinical Drug Therapy 10th Ed.+ PrepU Access Code
Pre-Owned ACSM's Resources for the Exercise Physiologist, 3e with PrepU $172.99

$17299
current price $172.99Pre-Owned ACSM's Resources for the Exercise Physiologist, 3e with PrepU
Pre-Owned Essentials of Pathophysiology 4e Text & PrepU Package $80.49

$8049
current price $80.49Pre-Owned Essentials of Pathophysiology 4e Text & PrepU Package
Pre-Owned Fader Burton's Microbiology for the Health Sciences 11th Edition Text + Prepu Package $93.99
$9399
current price $93.99Pre-Owned Fader Burton's Microbiology for the Health Sciences 11th Edition Text + Prepu Package
Pre-Owned NCLEX-RN 10,000 Printed Access Code - Powered by PrepU (Unknown) 1451116012 9781451116014 $111.77

$11177
current price $111.77Pre-Owned NCLEX-RN 10,000 Printed Access Code - Powered by PrepU (Unknown) 1451116012 9781451116014
Pre-Owned What is Life? A Guide to Biology with Physiology (Loose Leaf) & PrepU NonMajor Access Card

Pre-Owned What is Life? A Guide to Biology with Physiology (Loose Leaf) & PrepU NonMajor Access Card
Pre-Owned What Is Life? with Physiology, Prep-U & Bioportal Access Card $84.49

$8449
current price $84.49Pre-Owned What Is Life? with Physiology, Prep-U & Bioportal Access Card
Pre-Owned Abrams Clinical Drug Therapy 10e Text & PrepU Package $80.49

$8049
current price $80.49Pre-Owned Abrams Clinical Drug Therapy 10e Text & PrepU Package
Pre-Owned Essentials of Pathophysiology 4e Text & PrepU Package $84.49

$8449
current price $84.49Pre-Owned Essentials of Pathophysiology 4e Text & PrepU Package
Pre-Owned What is Life? A Guide to Biology with Physiology (Loose Leaf) & PrepU NonMajor Access Card $23.99 Was $106.25

Now$2399
current price Now $23.99, Was $106.25$106.25
Pre-Owned What is Life? A Guide to Biology with Physiology (Loose Leaf) & PrepU NonMajor Access Card
Pre-Owned What Is Life? with Physiology, Prep-U & Bioportal Access Card $88.49

$8849
current price $88.49Pre-Owned What Is Life? with Physiology, Prep-U & Bioportal Access Card
Other options to consider(82)
Pre-Owned What Is Life? a Guide to Biology W/Prep-U [With Prep-U] (Paperback) 1429223189 9781429223188 $9.99 Was $11.99
![Pre-Owned What Is Life? a Guide to Biology W/Prep-U [With Prep-U] (Paperback) 1429223189 9781429223188](https://i5.walmartimages.com/asr/9d6fcef1-01aa-4248-aaee-4f49bacce8c2_1.450dce16b732f35164bd1c18602ffadf.jpeg?odnHeight=576&odnWidth=576&odnBg=FFFFFF)
Now$999
current price Now $9.99, Was $11.99$11.99
Pre-Owned What Is Life? a Guide to Biology W/Prep-U [With Prep-U] (Paperback) 1429223189 9781429223188
Pre-Owned Taylor 9e Text & PrepU Package Paperback $83.04

$8304
current price $83.04Pre-Owned Taylor 9e Text & PrepU Package Paperback
Pre-Owned Maternity and Pediatric Nursing

Pre-Owned Maternity and Pediatric Nursing
Pre-Owned What Is Life? a Guide to Biology & Prep-U (Paperback) by Jay Phelan

Pre-Owned What Is Life? a Guide to Biology & Prep-U (Paperback) by Jay Phelan
Pre-Owned Medical Terminology : An Illustrated Guide

Pre-Owned Medical Terminology : An Illustrated Guide
Pre-Owned Psychiatric Mental Health Nursing $7.13 2.7 ¢/lb

$713
current price $7.132.7 ¢/lb
Pre-Owned Psychiatric Mental Health Nursing
Fundamentals of Nursing: Human Health and Function

Fundamentals of Nursing: Human Health and Function
Pre-Owned Essentials of Pathophysiology : Concepts of Altered States

Pre-Owned Essentials of Pathophysiology : Concepts of Altered States
Pre-Owned What Is Life? a Guide to Biology with Physiology & Prep-U (Paperback) 1464107254 9781464107252 Was $11.99

Pre-Owned What Is Life? a Guide to Biology with Physiology & Prep-U (Paperback) 1464107254 9781464107252
Pre-Owned Medical Terminology: An Illustrated Guide (Paperback) by Barbara Janson Cohen, Ann Depetris $6.73 Was $8.03

Now$673
current price Now $6.73, Was $8.03$8.03
Pre-Owned Medical Terminology: An Illustrated Guide (Paperback) by Barbara Janson Cohen, Ann Depetris
Bates' Nursing Guide to Physical Examination and History Taking

Bates' Nursing Guide to Physical Examination and History Taking
Lippincott's Nclex-PN Passpoint $198.99

$19899
current price $198.99Lippincott's Nclex-PN Passpoint
Pre-Owned The Official ACT Prep Guide 2024-2025: Book + 9 Practice Tests + 400 Digital Flashcards + Online Course, (Paperback) $7.29 Was $8.32

Now$729
current price Now $7.29, Was $8.32$8.32
Pre-Owned The Official ACT Prep Guide 2024-2025: Book + 9 Practice Tests + 400 Digital Flashcards + Online Course, (Paperback)
Best seller College Test Preparation Princeton Review Digital SAT Premium Prep, 2026: 6 Full-Length Practice Tests (3 in Book + 3 Adaptive Tests Online) + On, (Paperback) $21.68

$2168
current price $21.68From $17.86
College Test Preparation Princeton Review Digital SAT Premium Prep, 2026: 6 Full-Length Practice Tests (3 in Book + 3 Adaptive Tests Online) + On, (Paperback)
45 out of 5 Stars. 4 reviews
Pre-Owned Essentials of Maternity, Newborn, and Women's Health Nursing $6.55

$655
current price $6.55Pre-Owned Essentials of Maternity, Newborn, and Women's Health Nursing
Memmler's The Human Body in Health and Disease (Paperback) by Barbara Janson Cohen, Kerry Hull $7.24

$724
current price $7.24Memmler's The Human Body in Health and Disease (Paperback) by Barbara Janson Cohen, Kerry Hull
Best seller CDL Test Preparation CDL - Commercial Driver's License Exam, 2025-2026: Complete Prep for the Truck & Bus Driver's License Exams, (Paperback) From $14.11

From$1411
CDL Test Preparation CDL - Commercial Driver's License Exam, 2025-2026: Complete Prep for the Truck & Bus Driver's License Exams, (Paperback)
94.9 out of 5 Stars. 9 reviews
Best seller 2026/2027 ASVAB for Dummies: Book + 7 Practice Tests, Flashcards, and Videos Online, (Paperback) $25.50

$2550
current price $25.502026/2027 ASVAB for Dummies: Book + 7 Practice Tests, Flashcards, and Videos Online, (Paperback)
65 out of 5 Stars. 6 reviews
Related Products
Pre-Owned Practice Test for the KBIT 2 (Paperback) 099084854X 9780990848547
Pre-Owned Practice Test for the KBIT 2 (Paperback) 099084854X 9780990848547$46.60current price $46.60AAFCS Hospitality, Nutrition, & Food Science Exam Flashcard Study System: AAFCS Test Practice Questions & Review for the American Association of Family & Consumer Sciences Certification Examination
AAFCS Hospitality, Nutrition, & Food Science Exam Flashcard Study System: AAFCS Test Practice Questions & Review for the American Association of Family & Consumer Sciences Certification Examination$36.99current price $36.99


